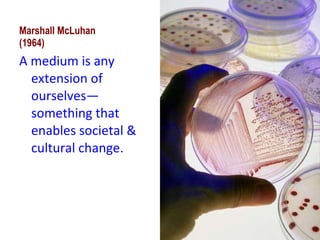
Marshall McLuhan (1964) A medium is any extension of ourselves—something that enables societal & cultural change.

The document discusses Marshall McLuhan's theory that "the medium is the message" and how new technologies introduce changes to human affairs and society in terms of scale, pace, and pattern. It provides examples of how print culture and electronic media affected fragmentation, centralization, and perceptions of time and space. McLuhan believed new technologies have "unanticipated consequences" and change social and cultural forms in non-obvious ways that people often fail to recognize. The document also examines McLuhan's views on the differences between oral, literate, and electronic eras and cultures.

![Marshall McLuhan (1964) SCALE PACE PATTERN “ the personal and social consequences of any medium – that is, of any extension of ourselves – result from the new scale [and pace and pattern] that is introduced into our affairs by each extension of ourselves or by any new technology” (107).](https://image.slidesharecdn.com/mcluhan-spring11-110316010931-phpapp01/85/Mc-luhan-spring11-11-320.jpg)























